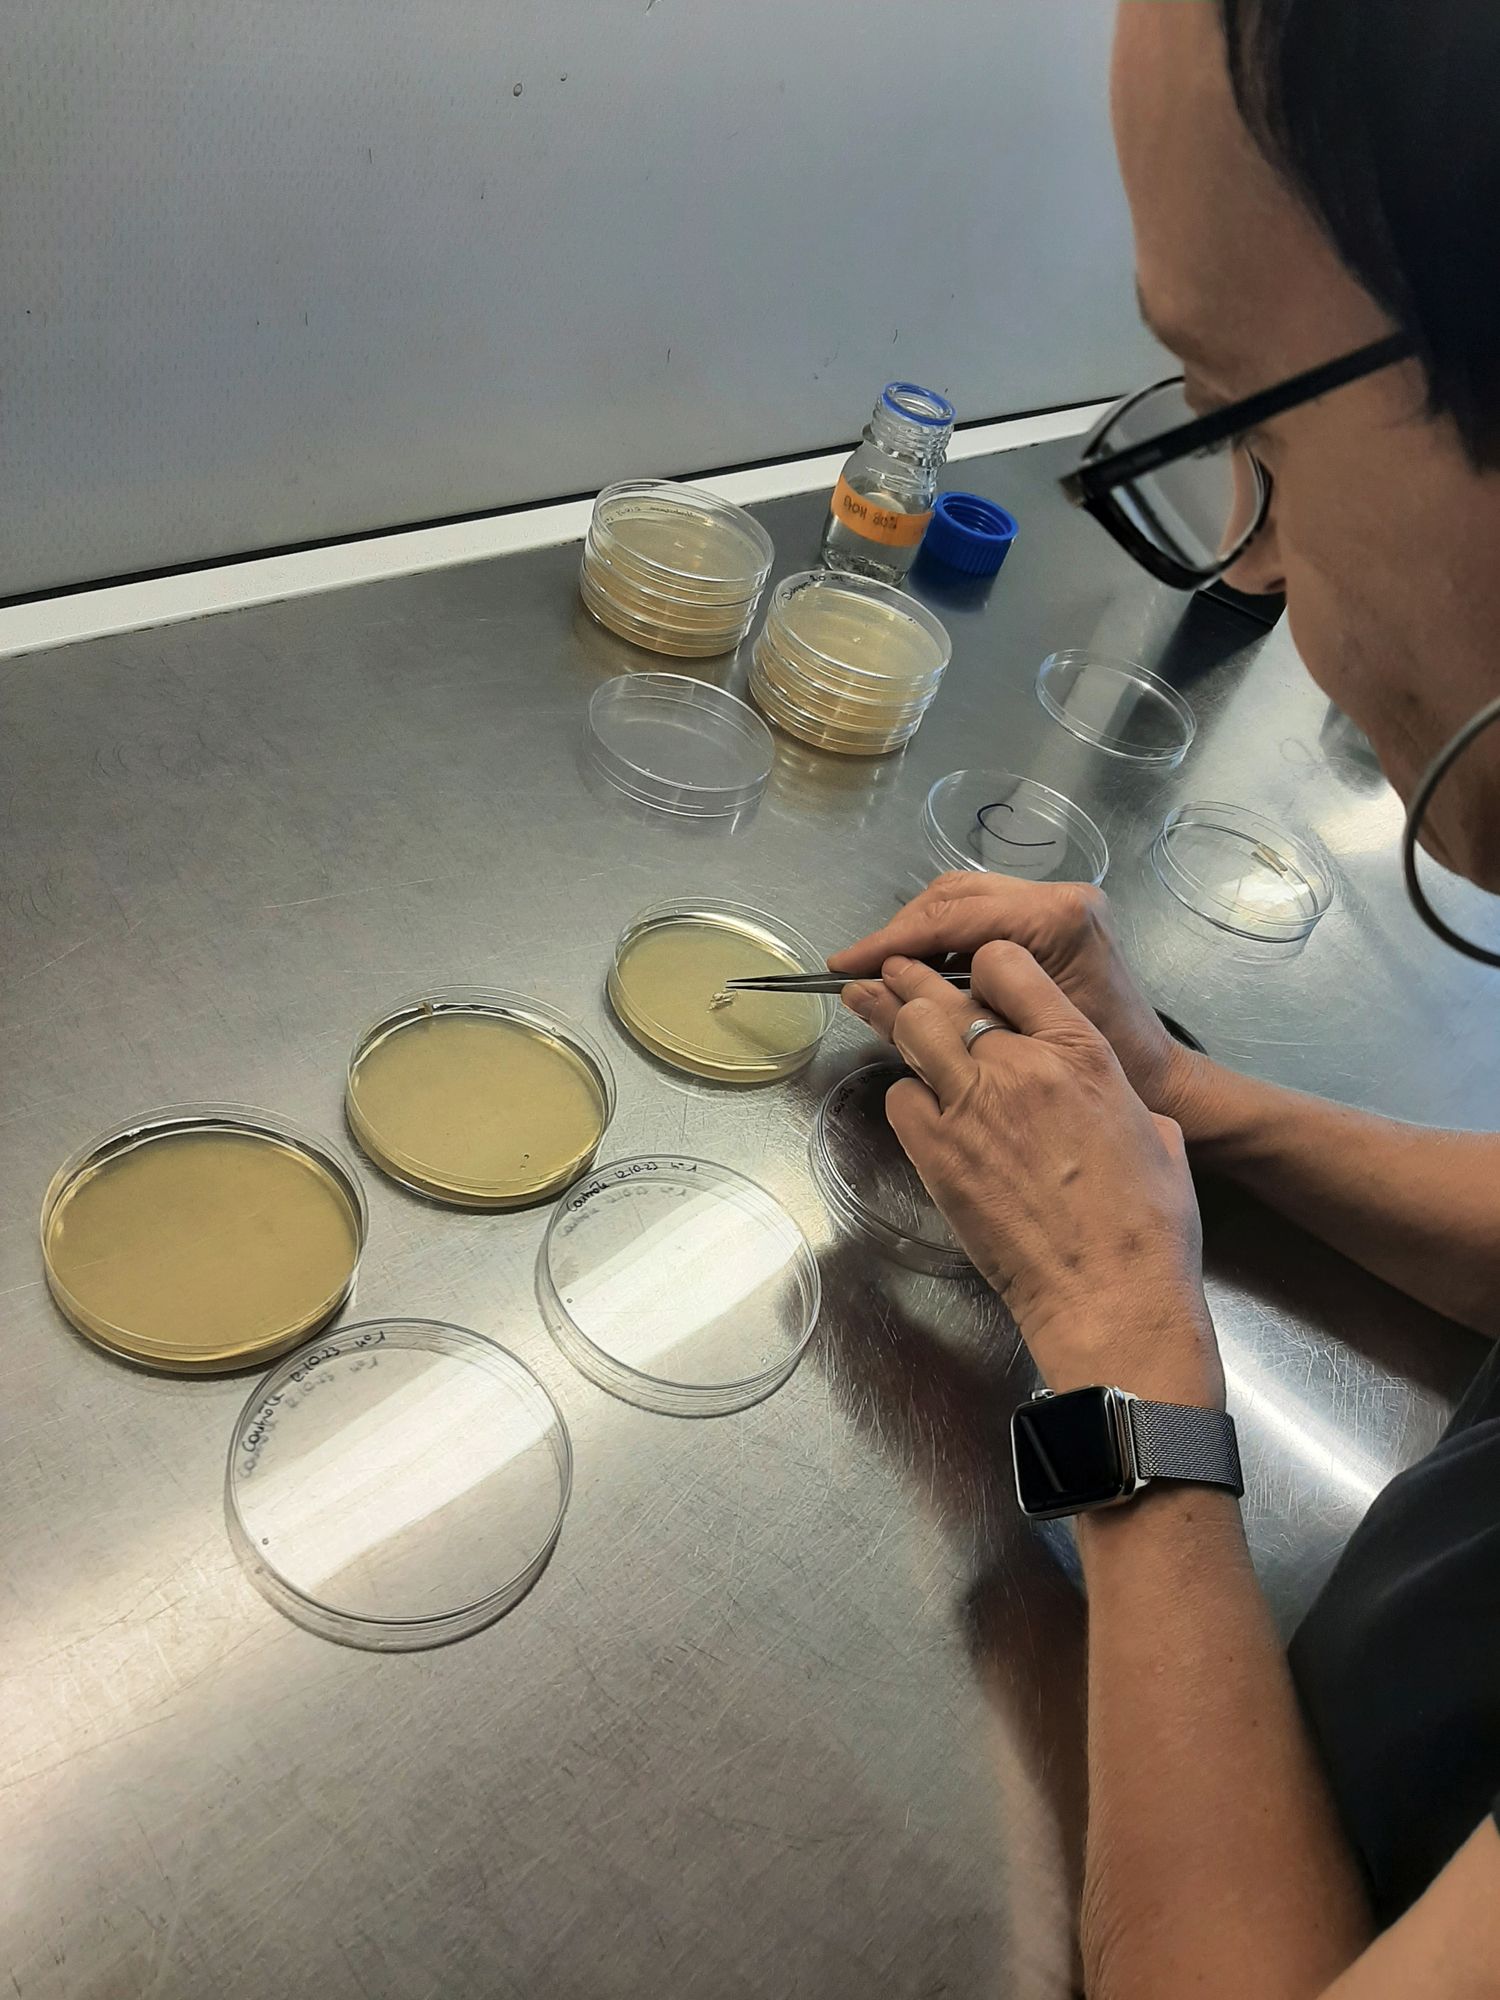

Des chercheurs ont ramené sur Terre des champignons de la stratosphère
Les champignons, on les cherche d’ordinaire dans les bois ou les prairies. Katia Gindro, responsable du Groupe mycologie d’Agroscope à Changins (VD), rêvait depuis longtemps de découvrir ceux qui peuplent les confins de la stratosphère.
Grâce à l’ingéniosité de Jérôme Kasparian, professeur dans le groupe de physique appliquée, et à l’Institut des sciences de l’environnement de l’Université de Genève, elle y est parvenue cette année, en tentant une expérience inédite: envoyer des ballons- sondes dans les airs depuis la station de MétéoSuisse à Payerne (VD).
Un dispositif très léger
Cinq ballons, transportant une boîte en polystyrène contenant quatre bâtonnets en bois enduits de vaseline qui tournoient, ont permis aux scientifiques de prélever des spores à de telles altitudes. «Ce dispositif devait être très léger pour atteindre la stratosphère, détaille la chercheuse. Il a également fallu trouver un moyen pour qu’il s’ouvre une fois arrivé à la bonne altitude, puis se referme avant de redescendre.»
+ d’infos www.agroscope.admin.ch; www.unige.ch
Vous voulez lire la suite de cet article ?
Profitez d'un accès illimité à toutes nos publications en format numérique

Les bonnes raisons de s'abonner
- · Accès à l'ensemble de nos contenus en ligne
- · Accès à des articles et des podcasts exclusifs
- · Accès à toutes nos éditions (e-paper)
- · Accès à nos hors-séries et suppléments (e-paper)
- · Accès à des avantages réservés à nos abonnés
Déjà abonné·e ? → Se connecter